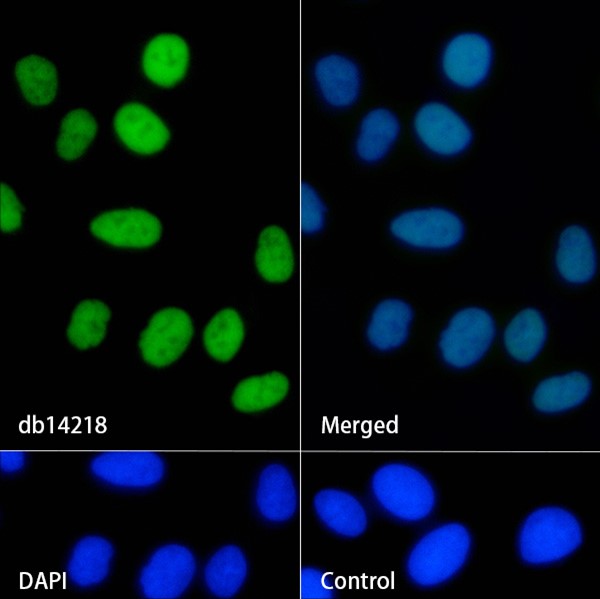

您当前的位置:
Conjugation/Formulation:Un-conjugated
- Background The protein encoded by this gene is part of the large ATP-dependent chromatin remodeling complex SWI/SNF, which is required for transcriptional activation of genes normally repressed by chromatin. The encoded protein, either alone or when in the SWI/SNF complex, can bind to 4-way junction DNA, which is thought to mimic the topology of DNA as it enters or exits the nucleosome. The protein contains a DNA-binding HMG domain, but disruption of this domain does not abolish the DNA-binding or nucleosome-displacement activities of the SWI/SNF complex. Unlike most of the SWI/SNF complex proteins, this protein has no yeast counterpart. [provided by RefSeq, Jul 2008]
- Immunogen A synthetic peptide of human BAF57
-
Gene ID
6605
-
Swiss Prot
Q969G3
- Synonyms CSS5; BAF57
- Reactivity Human,Mouse,Rat
- Application WB, IHC-P, ICC/IF, FC, IP
-
Recommended dilution
WB: 1:1000-1:5000
IHC-P: 1:200-1:500
ICC/IF: 1:200-1:500
FC: 1:10-1:100
IP: 1:10-1:100 - Calculated MW 47 kDa
- Observed MW 57 kDa
- Host species Rabbit
- Clonality Monoclonal
- Clonality No. DGR20799
- Isotype IgG
- Purity Affinity Purification
- Conjugation Un-conjugated
- Storage/Stability Store at -20°C. Supplied in 50mM Tris-Glycine(pH 7.4), 0.15M NaCl, 40% Glycerol, 0.01% sodium azide and 0.05% BSA. Stable for 12 months from date of receipt.
-
 Western blot analysis of extracts from Jurkat cells using db14218 at 1:1000.
Western blot analysis of extracts from Jurkat cells using db14218 at 1:1000. -
 Western blot analysis of extracts from HepG2,HCT116 cells and Rat spleen tissue using db14218 at 1:1000.
Western blot analysis of extracts from HepG2,HCT116 cells and Rat spleen tissue using db14218 at 1:1000. -
Immunofluorescence analysis of HeLa cells labelling BAF57 with db14218.
Immunofluorescence analysis of HeLa cells labelling BAF57 with db14218.
The cells were fixed with 4% PFA (10min, RT) followed by treatment with 0.1% Triton X-100 (10min, RT), and blocked in 1% BSA/10% normal goat serum/0.3M glycine in 0.1% PBS-Tween 20 for 1h. The cells were then incubate with db14218 (1:200) at room temprature for 1h, followed by a further incubation at room temperature for 45min with Goat Anti Rabbit lgG (H+L)-AF488 (db10005, shown in green). Nuclear DNA was labeled in blue with DAPI.
Control: Secondary antibody only.
订购信息
- Package Price (RMB)
- 10μL 398
- 20μL 698
- 50μL 1398
- 100μL 2398
- 货期:现货
相关产品
For research use only. Not intended for diagnostic.
